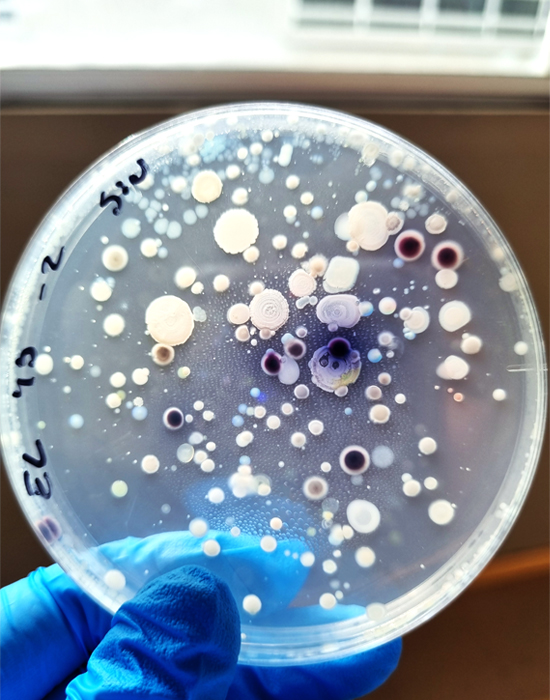
550x700

Programa Acreditado por 6 Años, por la Comisión Nacional de Acreditación.
Al Programa de Magíster en Ciencias Microbiología dictado por el Instituto de Biología de la Pontificia Universidad Católica de Valparaíso es un programa de carácter académico destinado a fortalecer la investigación en el área.

El programa está destinado fundamentalmente a estudiantes del área de las Ciencias Biológicas o carreras afines que quieran fortalecer sus habilidades de Investigación en todas las áreas de las Ciencias Microbiológicas:
El programa tiene una duración de cuatro semestres académicos. El plazo máximo para la obtención del grado es de cinco semestres.
Nuestro Programa de Magister en Ciencias Microbiológicas de la Pontificia Universidad Católica de Valparaíso, se encuentra “Acreditado por 6 Años, hasta Mayo del año 2026”, por la Comisión Nacional de Acreditación (CNA - Chile).